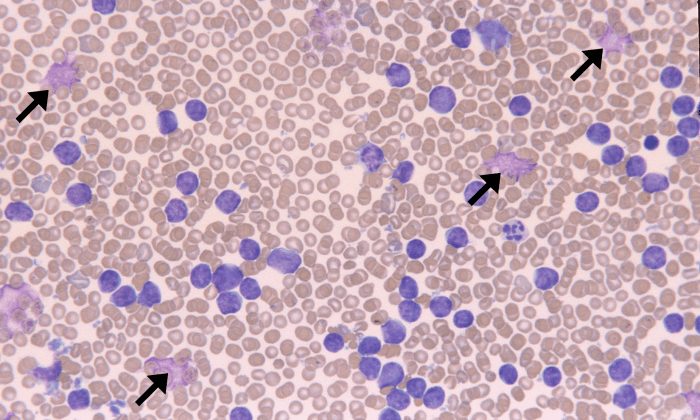
ALL 6 (Canine 5) ARROWS

ALL

Acute lymphocytic/lymphoblastic leukemia (ALL): markedly increased numbers of immature lymphoblasts on blood smear (lymphocytosis usually greater than 150 x 109/L). Lymphoblasts are large cells with prominent nucleoli and dark blue cytoplasm, and often rupture due to fragility (basket cells or smudge cells).